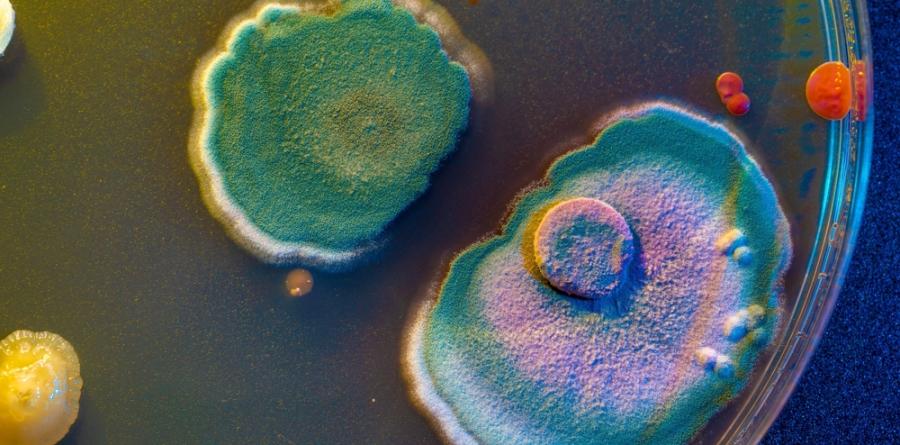

Микроб или вирус? Sukunaarchaeum пренаписва правилата на микробиологията
Учени от САЩ и Япония откриха микроб с вирусоподобен начин на живот и миниатюрен геном, който хвърля нова светлина върху границите между вируси и археи.
Учени от Университета на Минесота (САЩ) и Университета Цукуба (Япония) са открили нов микроб с необичаен начин на живот. Sukunaarchaeum, кръстен на японско божество с малък ръст, спада към археите, но притежава черти, наподобяващи вируси – изключително опростен геном и почти пълна зависимост от гостоприемника си, морските динофлагелати Citharistes regius.
Геном, съставен само от 238 000 базови двойки
Геномът на Sukunaarchaeum съдържа едва 238 000 базови двойки – по-малко от 5% от дължината на генома на Escherichia coli. От общо 189 гена, повечето са свързани с репликация, транскрипция и транслация на ДНК. Липсват разпознаваеми метаболитни пътища – микробът не може да синтезира аминокиселини или нуклеотиди самостоятелно.
„Този микроб е почти напълно лишен от метаболитни пътища,“ обяснява д-р Такуро Накаяма, член на изследователския екип. „Той разчита напълно на клетъчната машина на своя гостоприемник.“
Случайно откритие при секвениране
Откритието е направено по време на секвениране на ДНК на динофлагелати и симбиотични цианобактерии. Изследователите попадат на необичайна кръгова ДНК, която след повторни анализи се идентифицира като отделен, непознат досега организъм.
Потенциално нов клон в империята Archaea
Допълнителни анализи показват, че сходни генетични последователности присъстват в проби от морска вода по целия свят. Това предполага, че Sukunaarchaeum не е изолиран случай, а представител на цял нов клон в археите, чието еволюционно значение тепърва ще се проучва.
Следващи стъпки: микроскопия и анализ на протеини
Екипът работи по визуализирането на микроба с помощта на електронен микроскоп, но размерът под 1 микрон прави това предизвикателство. Учените също така се опитват да идентифицират функциите на необичайните му протеини – много от които нямат еквиваленти в познатите досега организми.
Значимост за науката
Откритието на Sukunaarchaeum разширява разбирането за границите между вируси и живи микроби и повдига въпроси за произхода и еволюцията на геномната минималност. То също така открива нови възможности за изследване на симбиотичните взаимоотношения в океанските екосистеми.